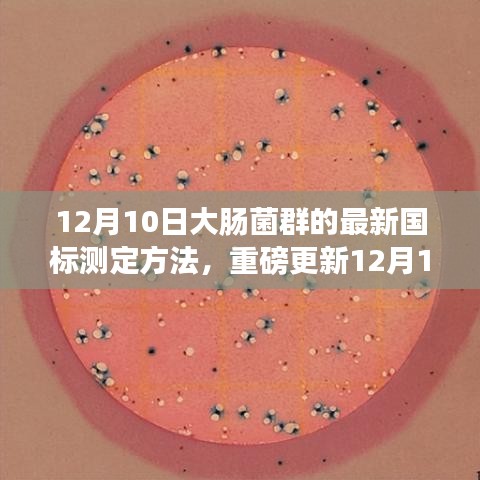

摘要:在最新更新的国标测定方法中,大肠菌群测定方法于12月10日迎来重磅更新。这一新方法将有助于更准确地监测食品中的大肠菌群数量,从而保障食品安全。掌握这一新方法对于确保食品质量和公众健康具有重要意义,开启了食品安全领域的新篇章。
开篇概述
随着食品行业的蓬勃发展,食品安全问题日益受到广泛关注,大肠菌群作为食品微生物学领域的重要研究对象,其测定方法的更新与改进直接关系到食品质量的评估与监控,本文将重点介绍12月10日最新发布的大肠菌群国标测定方法,为广大食品从业者、研究人员及消费者提供科学、实用的参考依据。
大肠菌群的重要性
大肠菌群是食品中常见的微生物指标之一,其存在与否及数量多少直接关系到食品的卫生质量,大肠菌群主要来源于人和温血动物的肠道,若食品中大肠菌群超标,可能意味着食品受到肠道致病菌的污染,从而对人体健康构成潜在威胁,准确、快速地测定食品中的大肠菌群对于保障食品安全具有重要意义。
最新国标测定方法解析
1、采样与保存:按照国家标准规定的方法采集食品样品,确保样品的代表性,并在规定的条件下保存,以避免大肠菌群数量的变化。
2、样品处理:采用适当的处理方法,如稀释、均质等,使食品中的大肠菌群得到有效释放,便于后续的测定。
3、培养与计数:根据最新国标要求,采用特定的培养基和培养条件,对大肠菌群进行培养并计数,新的国标方法更加注重实际操作的可行性和准确性,使得计数结果更加可靠。
4、结果判定:根据计数结果,结合国家标准中的限量规定,判断食品中的大肠菌群是否超标。
新国标测定方法的特点与优势
1、科学性:新的国标测定方法基于大量的实验数据和研究成果,具有更高的科学性。
2、实用性:新方法更加注重实际操作的可行性,使得广大食品从业者和研究人员能够更加方便地应用。
3、准确性:通过优化培养条件和计数方法,新国标测定方法的准确性得到了显著提高。
4、严谨性:新标准对测定过程中的各个环节都做出了明确规定,保证了测定结果的严谨性。
如何应用新国标测定方法
1、食品从业者:应严格按照新国标要求,对食品生产过程中的各个环节进行监控,确保产品符合卫生标准。
2、研究人员:应深入研究新国标测定方法,不断完善和优化实验条件,提高测定结果的准确性。
3、消费者:关注食品安全信息,了解大肠菌群等微生物指标的相关知识,选择安全、卫生的食品。
大肠菌群的测定对于保障食品安全具有重要意义,12月10日最新发布的大肠菌群国标测定方法,具有科学、实用、准确、严谨等特点,广大食品从业者、研究人员及消费者应密切关注并应用新国标测定方法,共同守护食品安全,为人们的健康保驾护航。
展望
随着科技的进步和食品安全需求的不断提高,大肠菌群等微生物指标的测定方法将不断更新和改进,我们将更加关注测定方法的简便性、快速性和自动化程度,为食品安全提供更加有力的技术支撑,让我们共同期待新的技术革新,为守护食品安全贡献力量。
转载请注明来自1608手游,本文标题:《掌握大肠菌群最新国标测定方法,守护食品安全新篇章,12月重磅更新!》

冀ICP备2023036363号-1
冀ICP备2023036363号-1
还没有评论,来说两句吧...